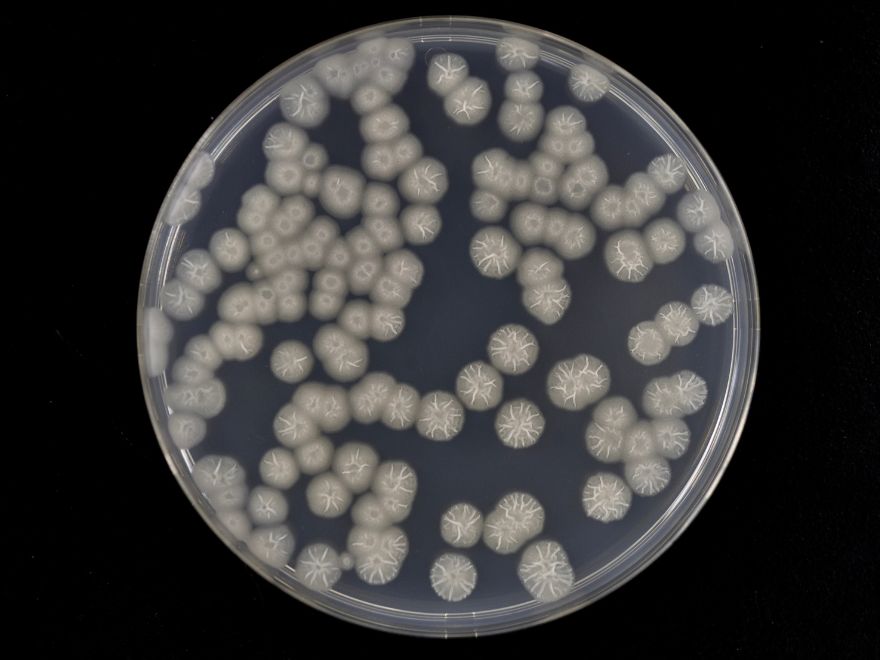

Seleccionar el sistema microbiano adecuado para la expresión de proteínas recombinantes es un paso crucial en los procesos biotecnológicos. Cada microorganismo —Pichia pastoris, Escherichia coli y Bacillus subtilis— ofrece ventajas y desafíos únicos, lo que los hace adecuados para diferentes aplicaciones. Desde un crecimiento rápido hasta modificaciones postraduccionales complejas, estos sistemas brindan soluciones personalizadas para diversas necesidades de producción de proteínas. Este artículo explora las fortalezas y limitaciones de cada organismo, ayudándote a tomar decisiones informadas para tus proyectos. En Cultiply, aprovechamos nuestra experiencia en ingeniería de bioprocesos y sistemas microbianos para optimizar cada etapa del proceso de producción de proteínas, garantizando eficiencia, escalabilidad y precisión.
Por qué los microorganismos son esenciales para la producción de proteínas recombinantes
Los microorganismos desempeñan un papel fundamental en la producción de proteínas recombinantes gracias a su eficiencia y adaptabilidad incomparables. Actuando como microfábricas, convierten instrucciones genéticas en proteínas funcionales con una velocidad y precisión notables. A diferencia de los sistemas basados en mamíferos o plantas, microorganismos como Pichia pastoris, Escherichia coli y Bacillus subtilis ofrecen plataformas rentables y escalables, lo que los hace indispensables en la investigación, las aplicaciones industriales y la industria farmacéutica.
Por ejemplo, el rápido crecimiento de E. coli permite reducir los tiempos de producción, mientras que Pichia pastoris destaca en la producción de proteínas con modificaciones postraduccionales complejas. A su vez, Bacillus subtilis secreta naturalmente proteínas al medio, lo que simplifica los procesos de purificación. Estas características hacen que los microorganismos sean ideales para la producción de enzimas, anticuerpos y proteínas terapéuticas.
En Cultiply, nos especializamos en comprender los matices de los sistemas de expresión microbianos. Adaptamos los procesos a las necesidades específicas de tu proteína para garantizar altos rendimientos, actividad óptima y una escalabilidad sin complicaciones. ¿El resultado? Innovación acelerada y una ventaja competitiva para tus proyectos biotecnológicos.
Diferencias clave entre Pichia pastoris, Escherichia coli y Bacillus subtilis
Pichia pastoris: alto rendimiento con modificaciones complejas
Pichia pastoris destaca como un sistema excepcional para la expresión de proteínas recombinantes cuando las modificaciones postraduccionales son una prioridad. Esta levadura es capaz de realizar glicosilaciones y otros procesos propios de organismos eucariotas, por lo que es ideal para producir proteínas terapéuticas y enzimas que requieren estructuras complejas.
A diferencia de los sistemas basados en células de mamífero, Pichia permite fermentaciones de alta densidad, alcanzando altos rendimientos sin comprometer la funcionalidad de las proteínas. Además, su adaptabilidad al entorno industrial es una ventaja clara: funciona tanto en ensayos a pequeña escala como en biorreactores industriales, con buena escalabilidad y mínimas modificaciones.
Tradicionalmente, emplea promotores inducibles por metanol, como AOX1, que permiten un control estricto de la expresión génica. No obstante, este enfoque plantea desafíos: la manipulación del metanol requiere experiencia técnica, y las condiciones de cultivo son más complejas y costosas que en sistemas bacterianos.
Para superar estas limitaciones, se han desarrollado sistemas alternativos en Pichia que no requieren inducción por metanol. Promotores como GAP (gliceraldehído-3-fosfato deshidrogenasa) permiten una expresión constitutiva, simplificando el proceso y reduciendo los riesgos y la complejidad operativa. Estos sistemas sin metanol ofrecen un enfoque más accesible y escalable, manteniendo altos rendimientos y funcionalidad.
A pesar de los desafíos, Pichia pastoris sigue siendo una opción fiable para aplicaciones que requieren proteínas de alta calidad con modificaciones estructurales complejas, cumpliendo con los estándares más exigentes de la industria.
Escherichia coli: crecimiento rápido a bajo coste
Reconocida por su simplicidad y eficiencia, Escherichia coli sigue siendo uno de los sistemas más populares para la producción de proteínas recombinantes. Su rápido crecimiento y la facilidad de manipulación genética permiten alcanzar una alta productividad en poco tiempo. Con un tiempo de duplicación de apenas 20 minutos en condiciones óptimas, E. coli permite una rápida validación de prototipos y escalado, siendo una opción económica para aplicaciones industriales.
Dispone de una gran variedad de herramientas moleculares, incluyendo promotores inducibles como T7, lo que aumenta su versatilidad para distintos tipos de proteínas. Además, es compatible con diversos sistemas de plásmidos, lo que facilita la expresión de un amplio abanico de proteínas.
Sin embargo, E. coli tiene sus limitaciones. No puede realizar modificaciones postraduccionales eucariotas, lo que reduce su utilidad en el caso de algunas proteínas terapéuticas. Además, altos niveles de expresión pueden derivar en la formación de cuerpos de inclusión, lo que requiere técnicas adicionales de replegado para recuperar proteínas funcionales. A pesar de estos inconvenientes, su velocidad, bajo coste y flexibilidad hacen de E. coli una herramienta clave en proyectos de producción de proteínas de forma rápida y rentable.
Bacillus subtilis: secreción natural para una purificación simplificada
Como bacteria grampositiva, Bacillus subtilis posee una ventaja única: la capacidad de secretar proteínas directamente al medio de cultivo. Esto simplifica enormemente los procesos de purificación, reduciendo el tiempo de producción y los costes asociados. Además, su estatus de “Generalmente Reconocida como Segura” (GRAS) la convierte en una opción preferida para aplicaciones alimentarias y farmacéuticas.
A diferencia de E. coli, Bacillus subtilis tiende a producir proteínas solubles, evitando la formación de cuerpos de inclusión y facilitando la obtención de productos funcionales. Esto la hace especialmente adecuada para la producción de enzimas y otros bioproductos industriales. También presenta una fisiología robusta, capaz de adaptarse a una amplia variedad de condiciones de cultivo, lo que garantiza su fiabilidad y escalabilidad.
No obstante, sus limitaciones en cuanto a modificaciones postraduccionales la hacen menos apropiada para ciertas proteínas terapéuticas. Además, alcanzar un rendimiento óptimo requiere ajustar cuidadosamente el sistema de expresión y la composición del medio. Aun así, Bacillus subtilis se distingue como un sistema eficiente, ideal para procesos basados en secreción.
Cómo elegir el sistema de expresión microbiana adecuado
Elegir el sistema óptimo de expresión microbiana implica equilibrar las necesidades específicas de tu proteína con las capacidades del organismo huésped. Deben considerarse factores como la necesidad de modificaciones postraduccionales, la escalabilidad, el coste y los plazos de producción.
- Si tu proteína requiere glicosilación u otras modificaciones eucariotas, Pichia pastoris es una excelente opción, aunque con mayores costes y requisitos técnicos.
- Para una producción rápida y económica de proteínas simples, Escherichia coli ofrece una velocidad y flexibilidad incomparables.
- Cuando la secreción de proteínas es clave para simplificar los procesos de purificación, Bacillus subtilis resulta ideal.

Colaborar con expertos, como el equipo multidisciplinar de Cultiply, puede hacer que este proceso de decisión sea más ágil y preciso. Nuestra experiencia en sistemas microbianos e ingeniería de bioprocesos garantiza un enfoque personalizado, optimizando el rendimiento y minimizando los cuellos de botella. Al evaluar cuidadosamente las características únicas de cada sistema y alinearlas con los objetivos del proyecto, es posible desbloquear todo el potencial de la producción de proteínas recombinantes con eficiencia, escalabilidad y control de costes.
Comparativa de sistemas de expresión microbiana: características clave
| Aspecto | Pichia pastoris | Escherichia coli | Bacillus subtilis |
| Ventajas principales | Alta densidad celular, realiza glicosilación, escalable, ideal para proteínas complejas | Crecimiento rápido, fácil manipulación genética, bajo coste, amplia gama de herramientas moleculares | Secreción natural de proteínas, estatus GRAS, adecuado para fermentación industrial |
| Limitaciones principales | Requiere optimización precisa de las condiciones de cultivo, mayor coste que sistemas bacterianos | Modificaciones postraduccionales limitadas, formación de cuerpos de inclusión en algunas proteínas | Modificaciones postraduccionales limitadas, requiere optimización específica según la cepa |
| Modificaciones postraduccionales | Sí, realiza glicosilación similar a la eucariota | No (mínimas o inexistentes) | No (mínimas o inexistentes) |
| Secreción de proteínas | Moderada, requiere condiciones específicas | Limitada (generalmente intracelular) | Alta (secreta proteínas al medio extracelular) |
| Velocidad de crecimiento | Moderada (tiempo de duplicación ~2 horas) | Muy rápida (tiempo de duplicación ~20 min) | Moderada (~30–60 min de tiempo de duplicación) |
| Eficiencia de costes | Moderada a alta (inversión inicial más alta, pero escalable a nivel industrial) | Muy baja (el sistema más económico) | Baja a moderada (competitivo para producción a gran escala) |
| Escalabilidad | Alta (adecuado para uso industrial) | Alta | Alta |
| Aplicaciones ideales | Producción de proteínas terapéuticas, enzimas que requieren glicosilación | Enzimas, proteínas terapéuticas simples, proteínas recombinantes simples | Enzimas industriales, producción masiva de proteínas solubles |















